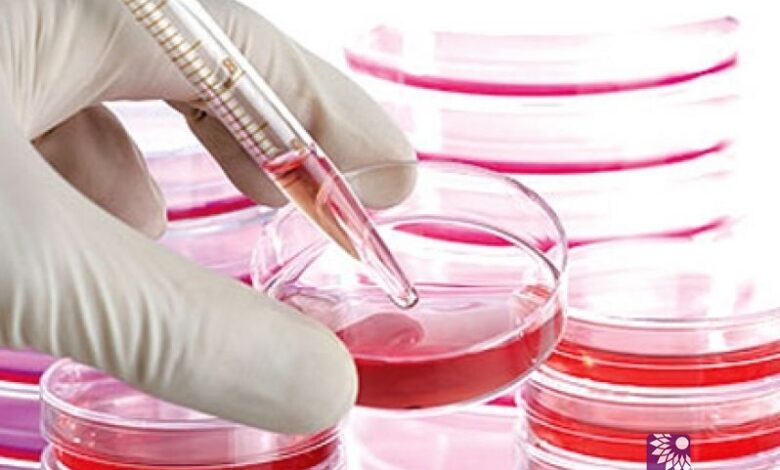

استخدام الخلايا الجذعية لعلاج مشاكل الخصوبة
الفجر الجديد – تمكن باحثون يابانيون يعملون في مجال الخلايا الجذعية من التوصل إلى طريقة لإنماء بويضات وحيوانات منوية عند فئران التجارب، مستخدمين لذلك خلايا جذعية، الأمر الذي يمثل نقطة تحول في علاجات الخصوبة.
ويأمل العلماء أن يساعد نجاح هذه التجربة عند البشر السيدات في سن الثلاثين والأربعين ليصبحن أمهات. كما يمكن لهذه التقنية الحديثة أن تساعد الأشخاص الناجين من السرطان والذين عانوا عطباً في أجهزتهم التناسلية نتيجة العلاج الكيمائي من أن يتمكنوا مجدداً من الإنجاب.
يذكر أن ما يقرب من 10% من السيدات في أمريكا يعانين صعوبة ما في أن يصبحن أمهات.
وقالت تريزا ودراف، رئيسة قسم الحفاظ على الخصوبة في جامعة نورثويست: "تقدم هذه الدراسات مجموعة من الأدلة الجديدة التي تؤكد إمكانية التغلب على مشاكل العقم من خلال التدخل بتقنية الخلايا الجذعية".
ومن جهتها شرحت باحثة الخلايا الجذعية رنيه ريجو بيرا أن محاولة استخدام الخلايا الجذعية لإنماء بويضات جديدة تمثل تحدياً حقيقياً، إذ إن السيدات يولدن بمقدار محدد من البويضات ولا ينتجن المزيد متى وصلن لسن اليأس.
وأضافت: "بطريقة ما تمثل هذه التقنية الجديدة لعلاج العقم وسيلة لإرجاع الساعة البيولوجية لهؤلاء السيدات للخلف للتمتع بالإنجاب مرة أخرى".
يذكر أن عدة محاولات سابقة لاستخدام الخلايا الجذعية من أجل خلق حيوانات منوية وبويضات باءت بالفشل.





